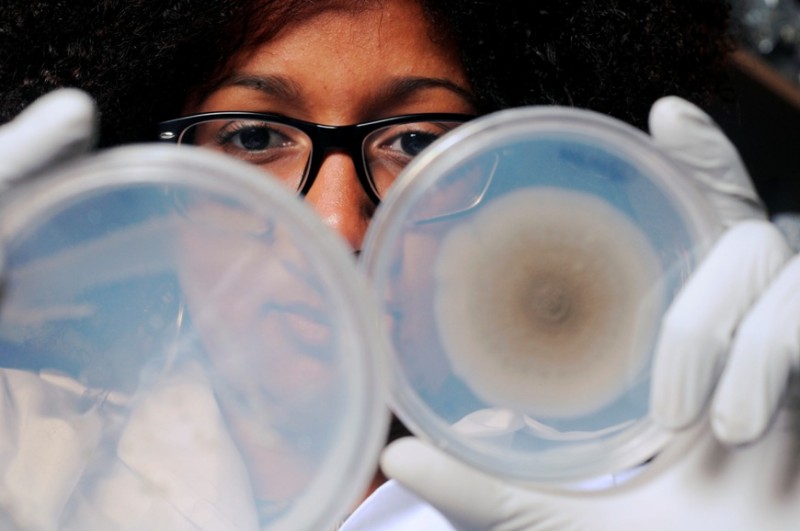
Encuentran vida en forma de bacterias a 10 kilómetros de la superficie de la Tierra Encuentran vida en forma de bacterias a 10 kilómetros de la superficie de la Tierra

Investigadores del Instituto de Tecnología de Georgia han anunciado la detección de microbios, bacterias a 10 kilómetros sobre la superficie de la Tierra. Según el estudio, en la troposfera se encontrarían microorganismos que podrían ser actores principales en la influencia sobre el clima en el planeta.
De acuerdo a Kostas Konstantinidis, microbiólogo coautor del estudio, detectaron un gran número de microorganismos en la atmósfera (de 8 a 15 kilómetros) sobre la superficie de la Tierra. Unos resultados que sugieren que en la atmósfera existe un constante cambio.
Algunos de los microbios parecen ser "visitantes" transitorios, en cambio, un número significativo de estas pequeñas formas de vida son probablemente capaces de sobrevivir y de alguna manera "alimentarse" de sustancias orgánicas o contenidos en carbono de productos químicos que flotan en lo alto de la atmósfera. Según Konstantinidis:
Hay algunas especies que son abundantes. Esto podría llegar a ser realmente interesante, ¿qué son todas esas células allí? ¿cómo sobreviven? Quizá es demasiado pronto aún para saber la respuesta a estas preguntas.
Para llevar a cabo el estudio los científicos recolectaron muestras de las bacterias a través de un avión a reacción (con un filtro de partículas), nueve vuelos alrededor de Estados Unidos y cercanías, en su mayoría sobre el Golfo de México y el Mar Caribe antes, durante y después de los huracanes Karl y Earl en el 2010.
Luego pasaron a analizar el ADN de las muestras y a secuenciar sus genes obteniendo como resultado que alrededor del 60% de las células de las muestras seguían con vida. La pregunta que se hace a partir de aquí la comunidad es la influencia que pueden tener sobre el clima del planeta. Muchos de los microbios que se encuentran en el cielo son similares a los de los océanos y ambientes de agua dulce.
Podría ser que algunos de ellos fueran patógenos. Aún así, no está claro debido al análisis genético, ya que no pudimos precisar la especie exacta de bacterias. Esto podría representar una forma desconocida para la propagación de enfermedades.
Y es que el estudio concluye que por alguna razón desconocida, la proporción de estas bacterias a 10 kilómetros sobre la superficie de la Tierra, en relación con otras partículas como el polvo, es mayor en las zonas altas de la atmósfera. Un trabajo que ahora busca determinar si los microbios son importantes para el funcionamiento de la atmósfera, a los cambios climáticos o incluso a la hora de ayudar a formar nubes y alterar su química.
Fuente: alt1040.com